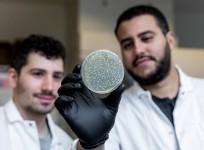

Science & Health


Pregnant Women Vaccinated Against COVID-19 Pass Protection to Their Newborns; High Levels of Antibodies Found In Infants [Study]

Velociraptor and T-Rex Wagged Their Tails While Running; New Simulation Reveals Role of Tail In Bipedal Dinosaur Movement [Study]

New DNA sensor rapidly discerns infectious state of virus; detects SARS-CoV-2, Human Adenovirus [details]

Drug abuse, depression among teens is common but new "climate anxiety" joins the list now [Study]

SARS-COV-2 can be entirely eradicated with this intelligent fiber mask
Scientists discover a new bacterial enzyme that specifically targets RNA

Time to remap Ring of Fire? 5.8 M earthquake hits Australia's Victoria region

Potential breakthrough in novel cancer therapy; new way of reversing immune suppression in tumors found [Explained]

Phytoplasma-produced molecules can interfere with plant growth

Come September, NASA's Mars Mission 2020 and China's Tainwen-1 go into safe mode; Here's why

Cost effective and environment-friendly oil absorbing cotton developed by IIT Guwahati

Mars helicopter captures pictures of rare Mars rock, helps develop 3D model by NASA scientists

Spice is significantly more harmful than marijuana [Study]

Whitest Paint In the World: Ultra-white Reflective Paint By Purdue Scientists Enters Guinness World Records; Has Potential To Cool Buildings in Future [Details]
Advertisement
Advertisement